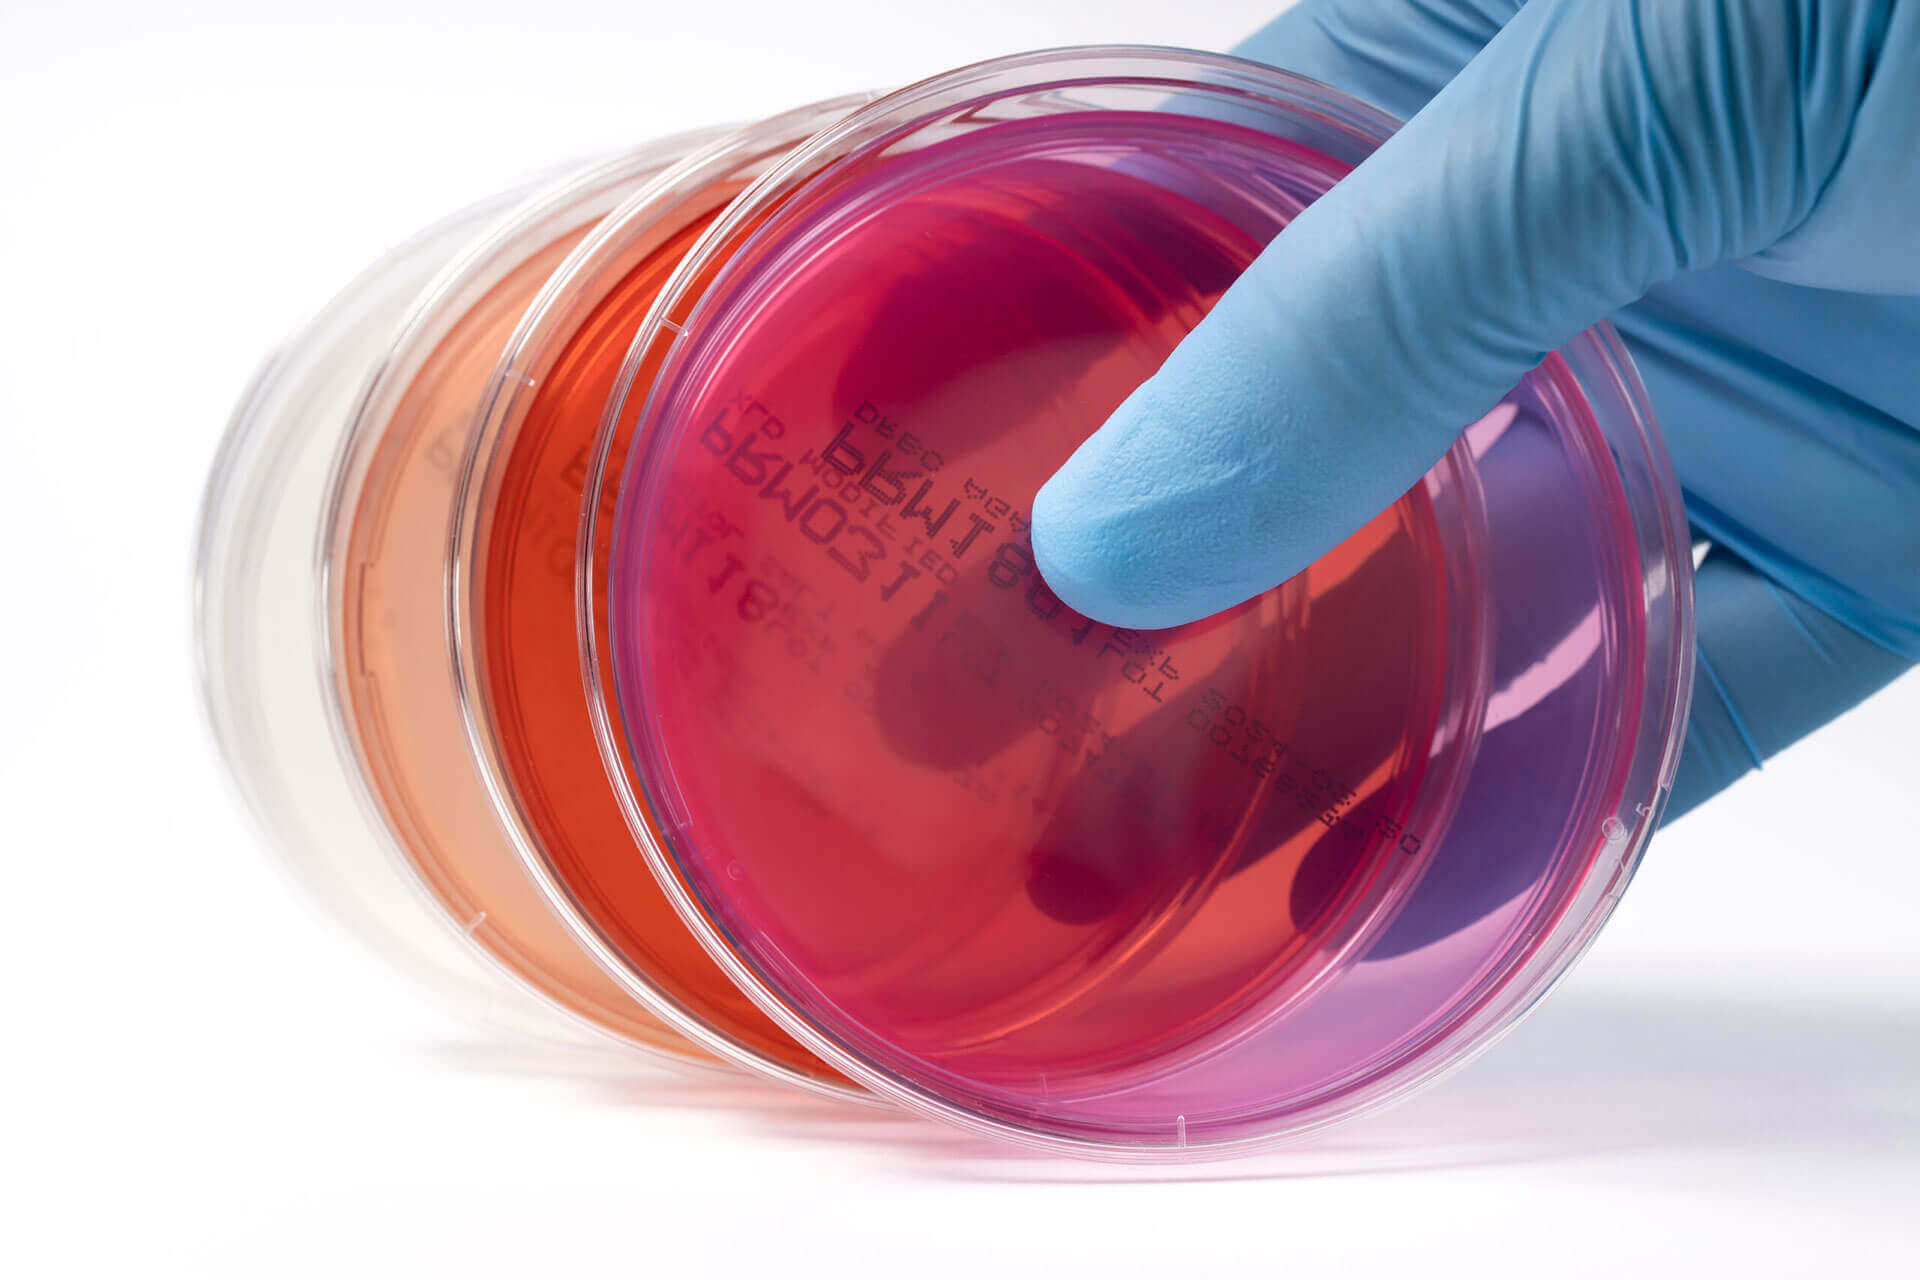

- Culture Media

- Ready to Use Media Plate
- Dehydrated Media

Bangladesh Labware Corporation, your premier destination for a comprehensive range of cutting-edge microbial products. With an unwavering commitment to excellence and innovation, we specialize in offering a diverse array of high-quality items tailored to meet the unique needs of various industries.
Our extensive product portfolio includes an array of essential microbial solutions, ranging from biological media bases and Dehydrated Culture Media to Supplements, Antibiotic Discs, and an assortment of Ready-to-Use media and Absolute EM solutions. Whether you’re in the pharmaceutical, clinical, food, cosmetics, veterinary, agriculture, biotechnology, or fermentation industry, we have the perfect microbial products to support your endeavors.
As proud partners and authorized distributors of TITAN BIOTECH LTD., a leading biosciences company with over three decades of industry experience, we bring you unparalleled access to their esteemed range of microbiological products. TITAN BIOTECH LTD. has earned widespread recognition for its relentless pursuit of excellence, leveraging extensive research and the latest technological advancements to deliver cutting-edge solutions to the microbial community.
Our commitment to quality is reflected in our adherence to the highest industry standards and certifications, including ISO 9001, GMP, ISO 11133, ISO 13485, and more. These accreditations underscore our dedication to providing you with products of uncompromising quality, reliability, and consistency.
At Bangladesh Labware Corporation, we take pride in our collaborative partnerships with renowned brands, ensuring the best-in-class microbial solutions.
Contact us today to learn more about how we can support your microbial needs and elevate your research and production processes to new heights of success.